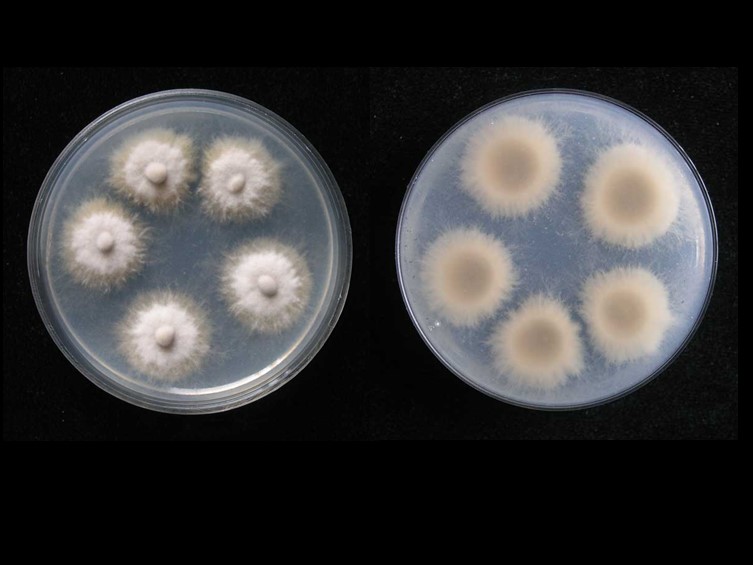

Habitat:
Underside of leaves.
Host:
Hymenoptera: Vespidae.
Description:

Stroma arising from various parts of the head, thorax and abdomen, including legs. Stroma slender, terete, attenuated upward, light to dark brown. 
Perithecia concentrated terminally or subterminally, pseudo-immersed in loosely interwoven hyphae, ovoid, 320–380 × 150–240 μm. 
Asci cylindrical, 150–215 × 7–8 μm. 
Ascospores whole, filiform, multi-septate, 125–165 × 2–3 μm. Asexual morph: Synnemata simple, dark, cylindrical. 
Conidiogenous cells monophialidic, septate, scattered to moderately crowded, arose laterally from the synnemata, with cylindrical to ellipsoid bases, 15–44 × 1.5–2 μm. 
Conidia hyaline, smooth, one-celled, lemon-shaped, 8.5–10.5 × 2–5.5 μm, with mucoid sheath.
Culture characteristics:
Colonies on PDA attaining a diam 10 mm in 30 d, gray to gray brown with a hyaline margin immersed in the agar.
Species |
Strain |
Compound |
Pubchem CID |
Biological activity |
Reference |
|---|
|
Strain |
|---|